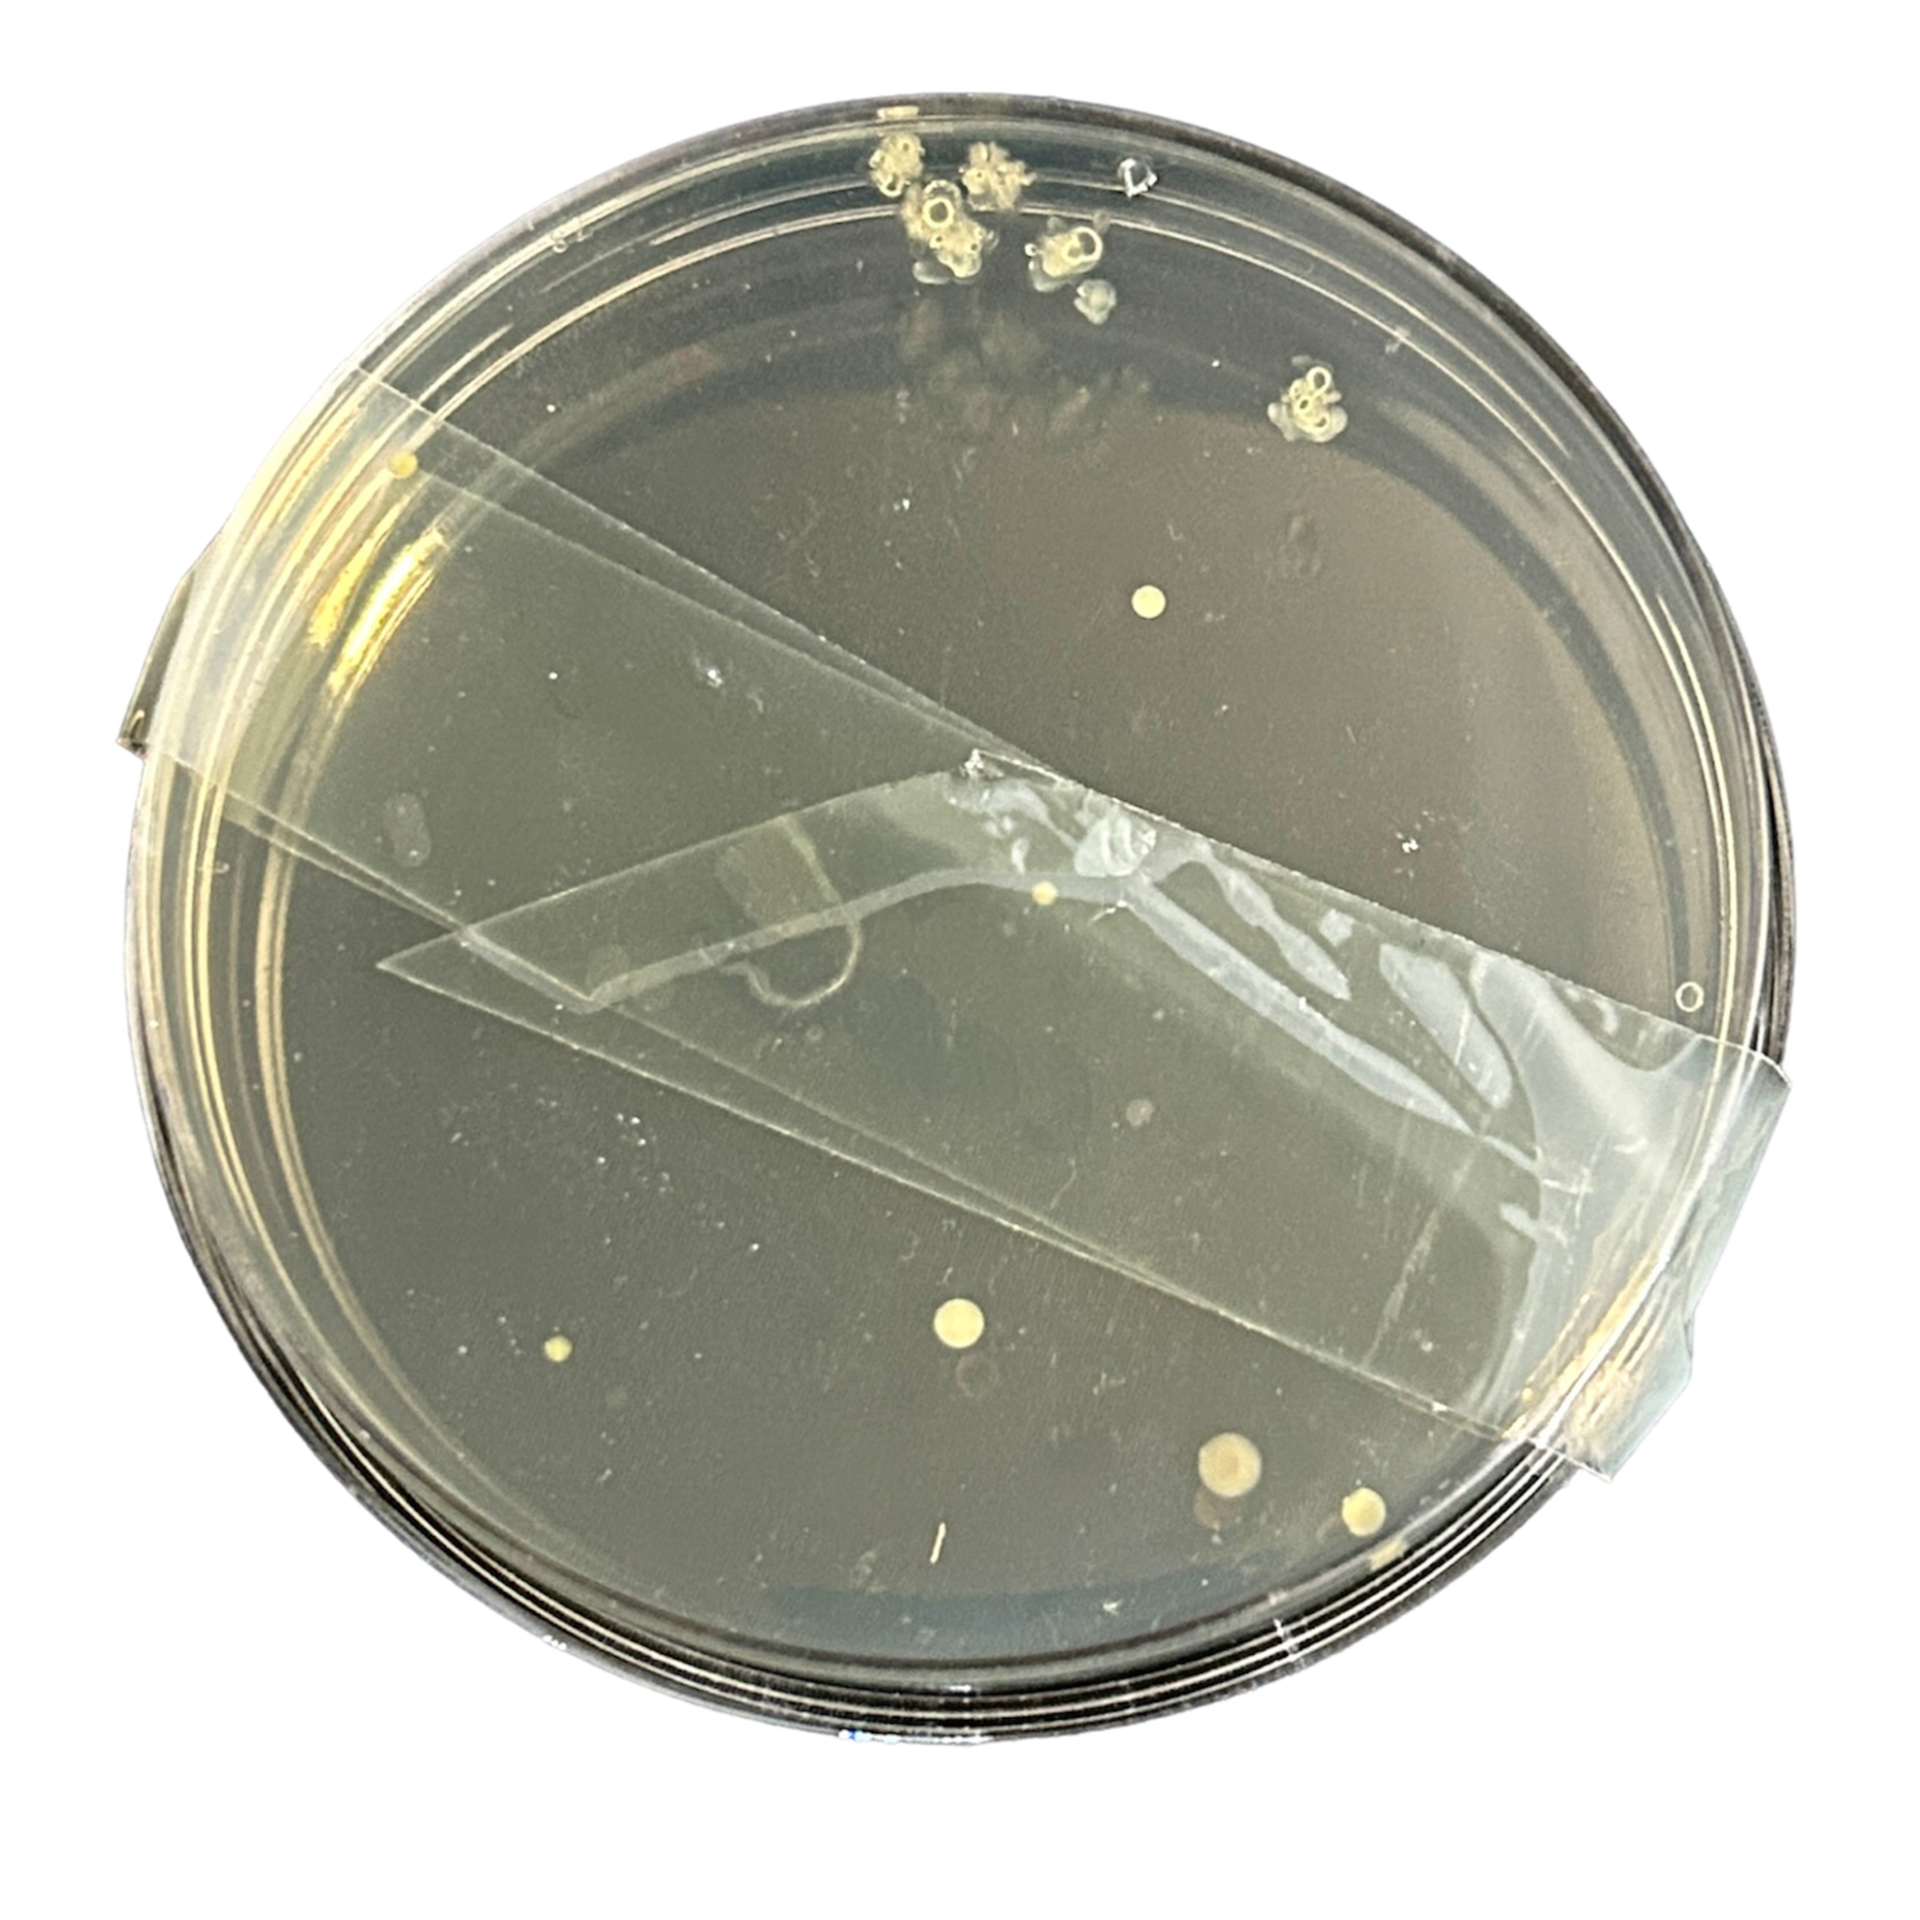
Bedroom Carpet
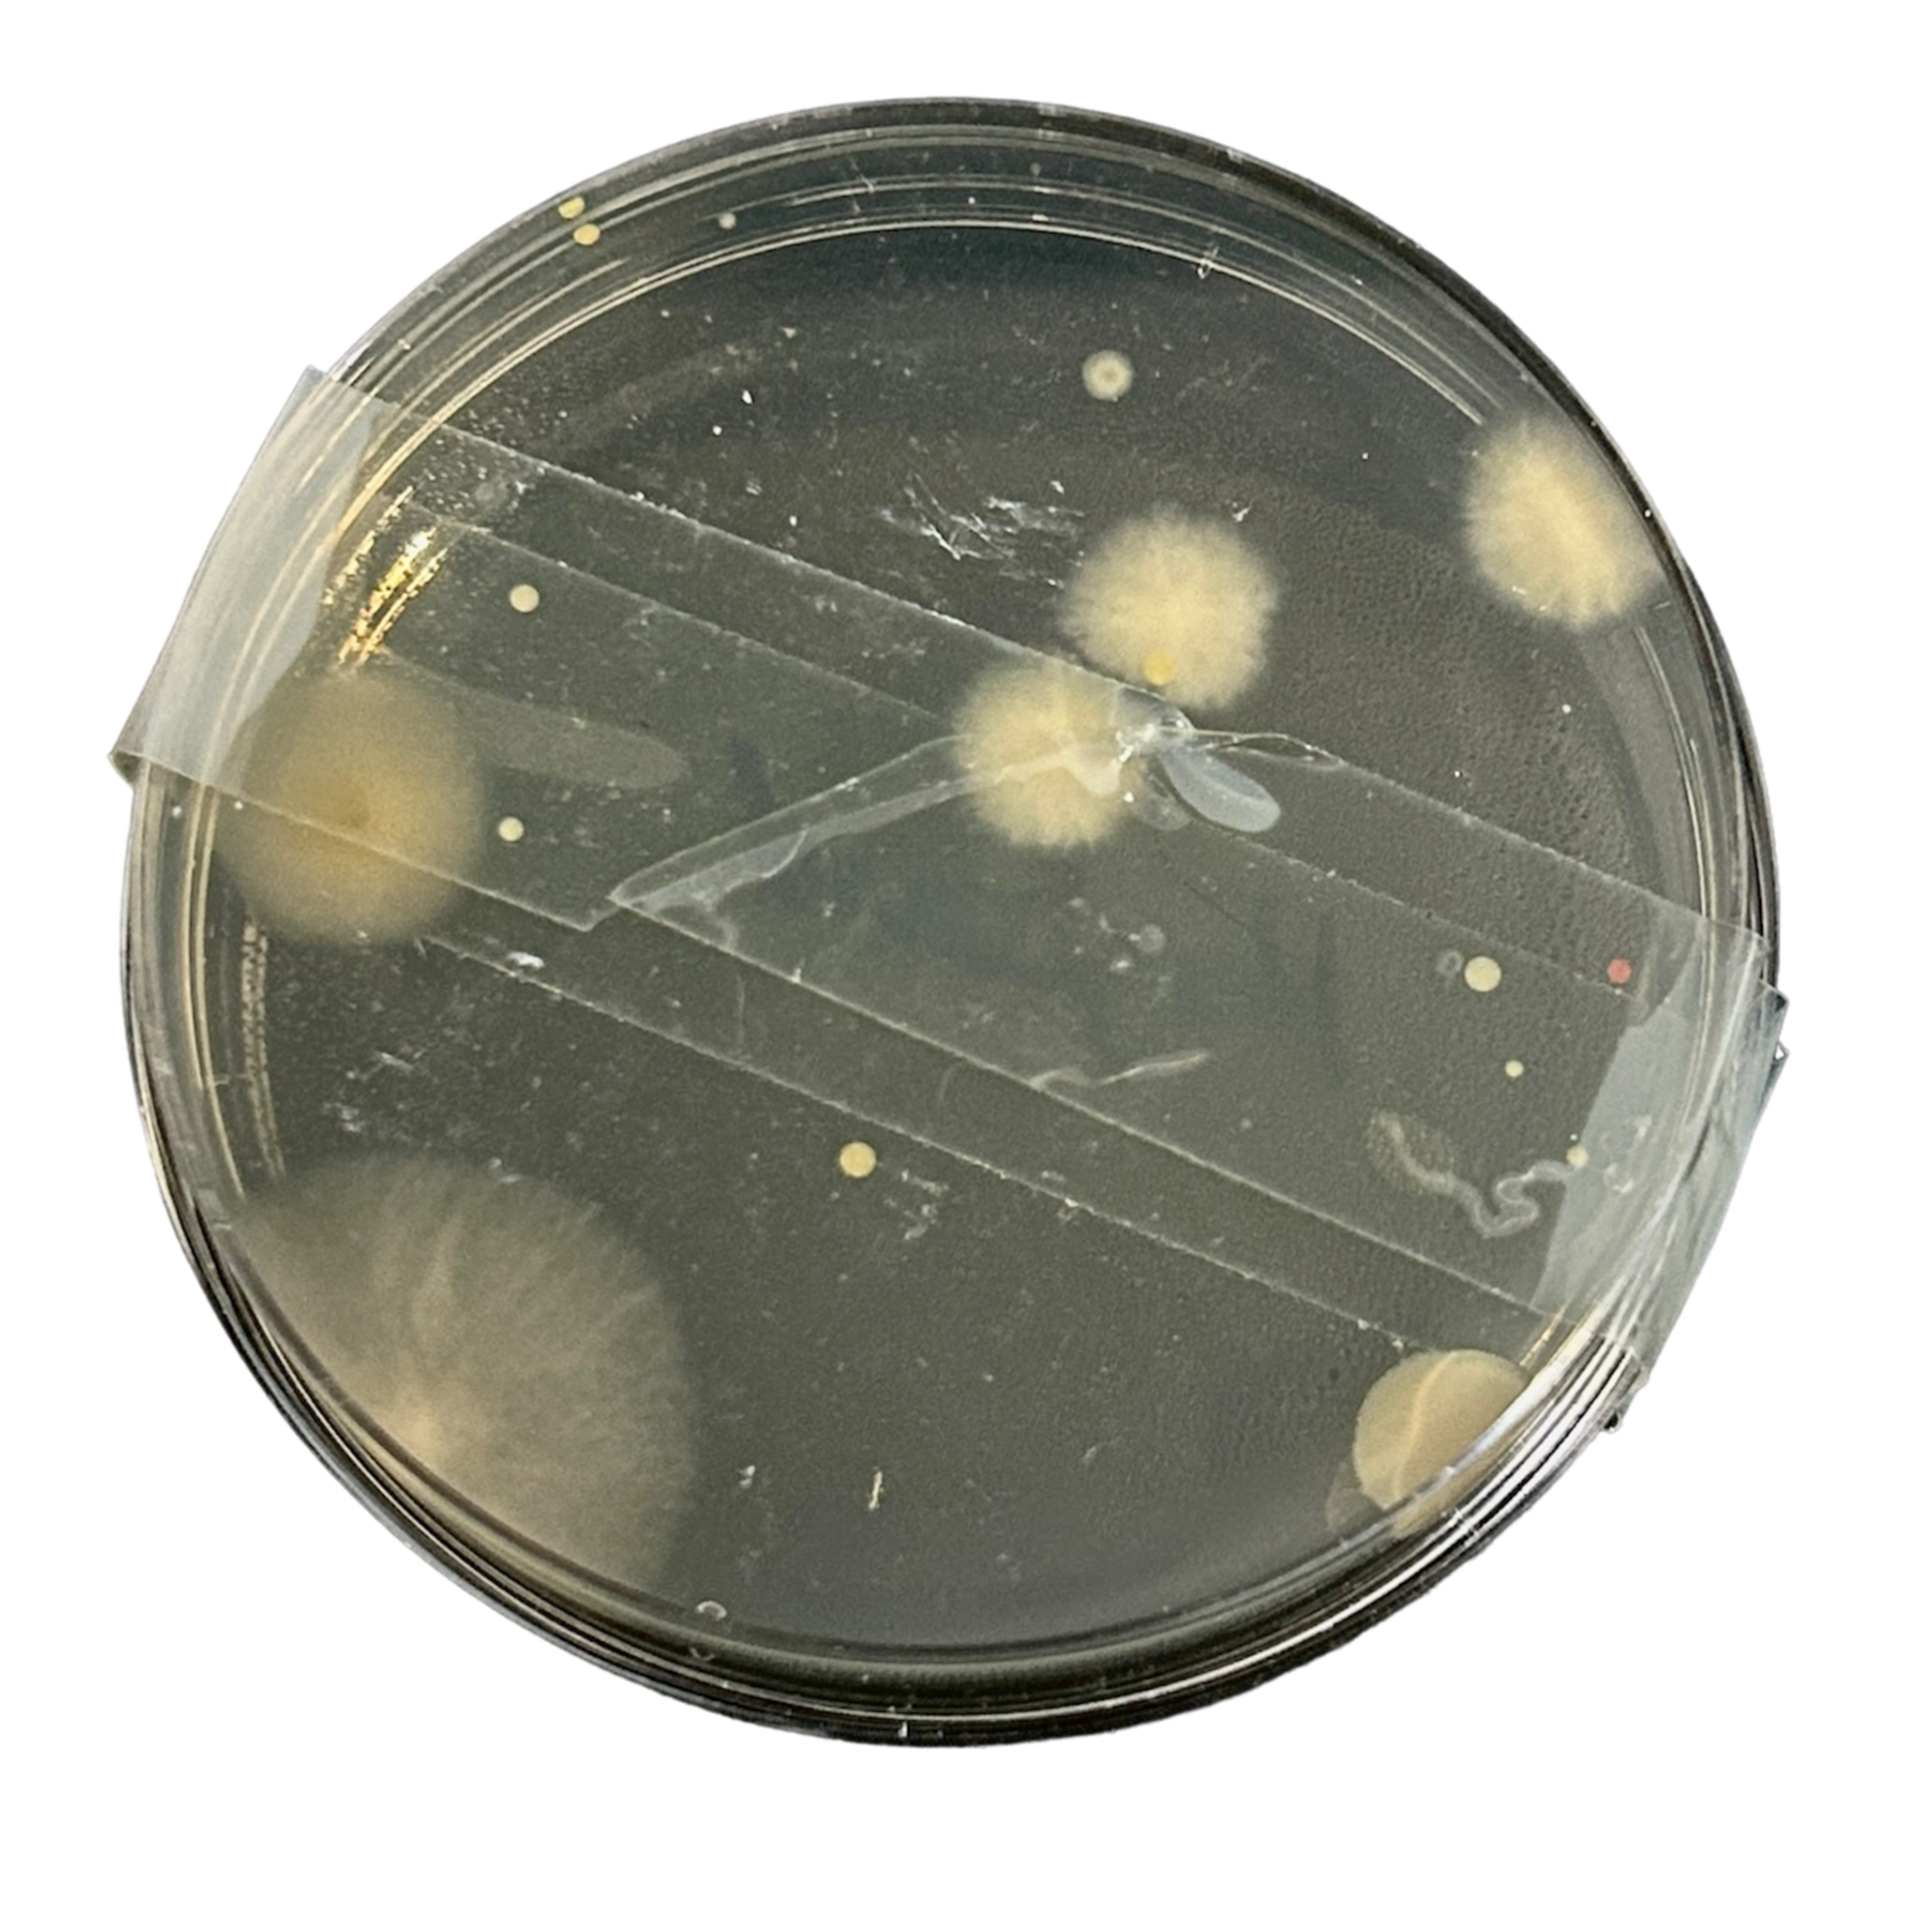
Keyboard
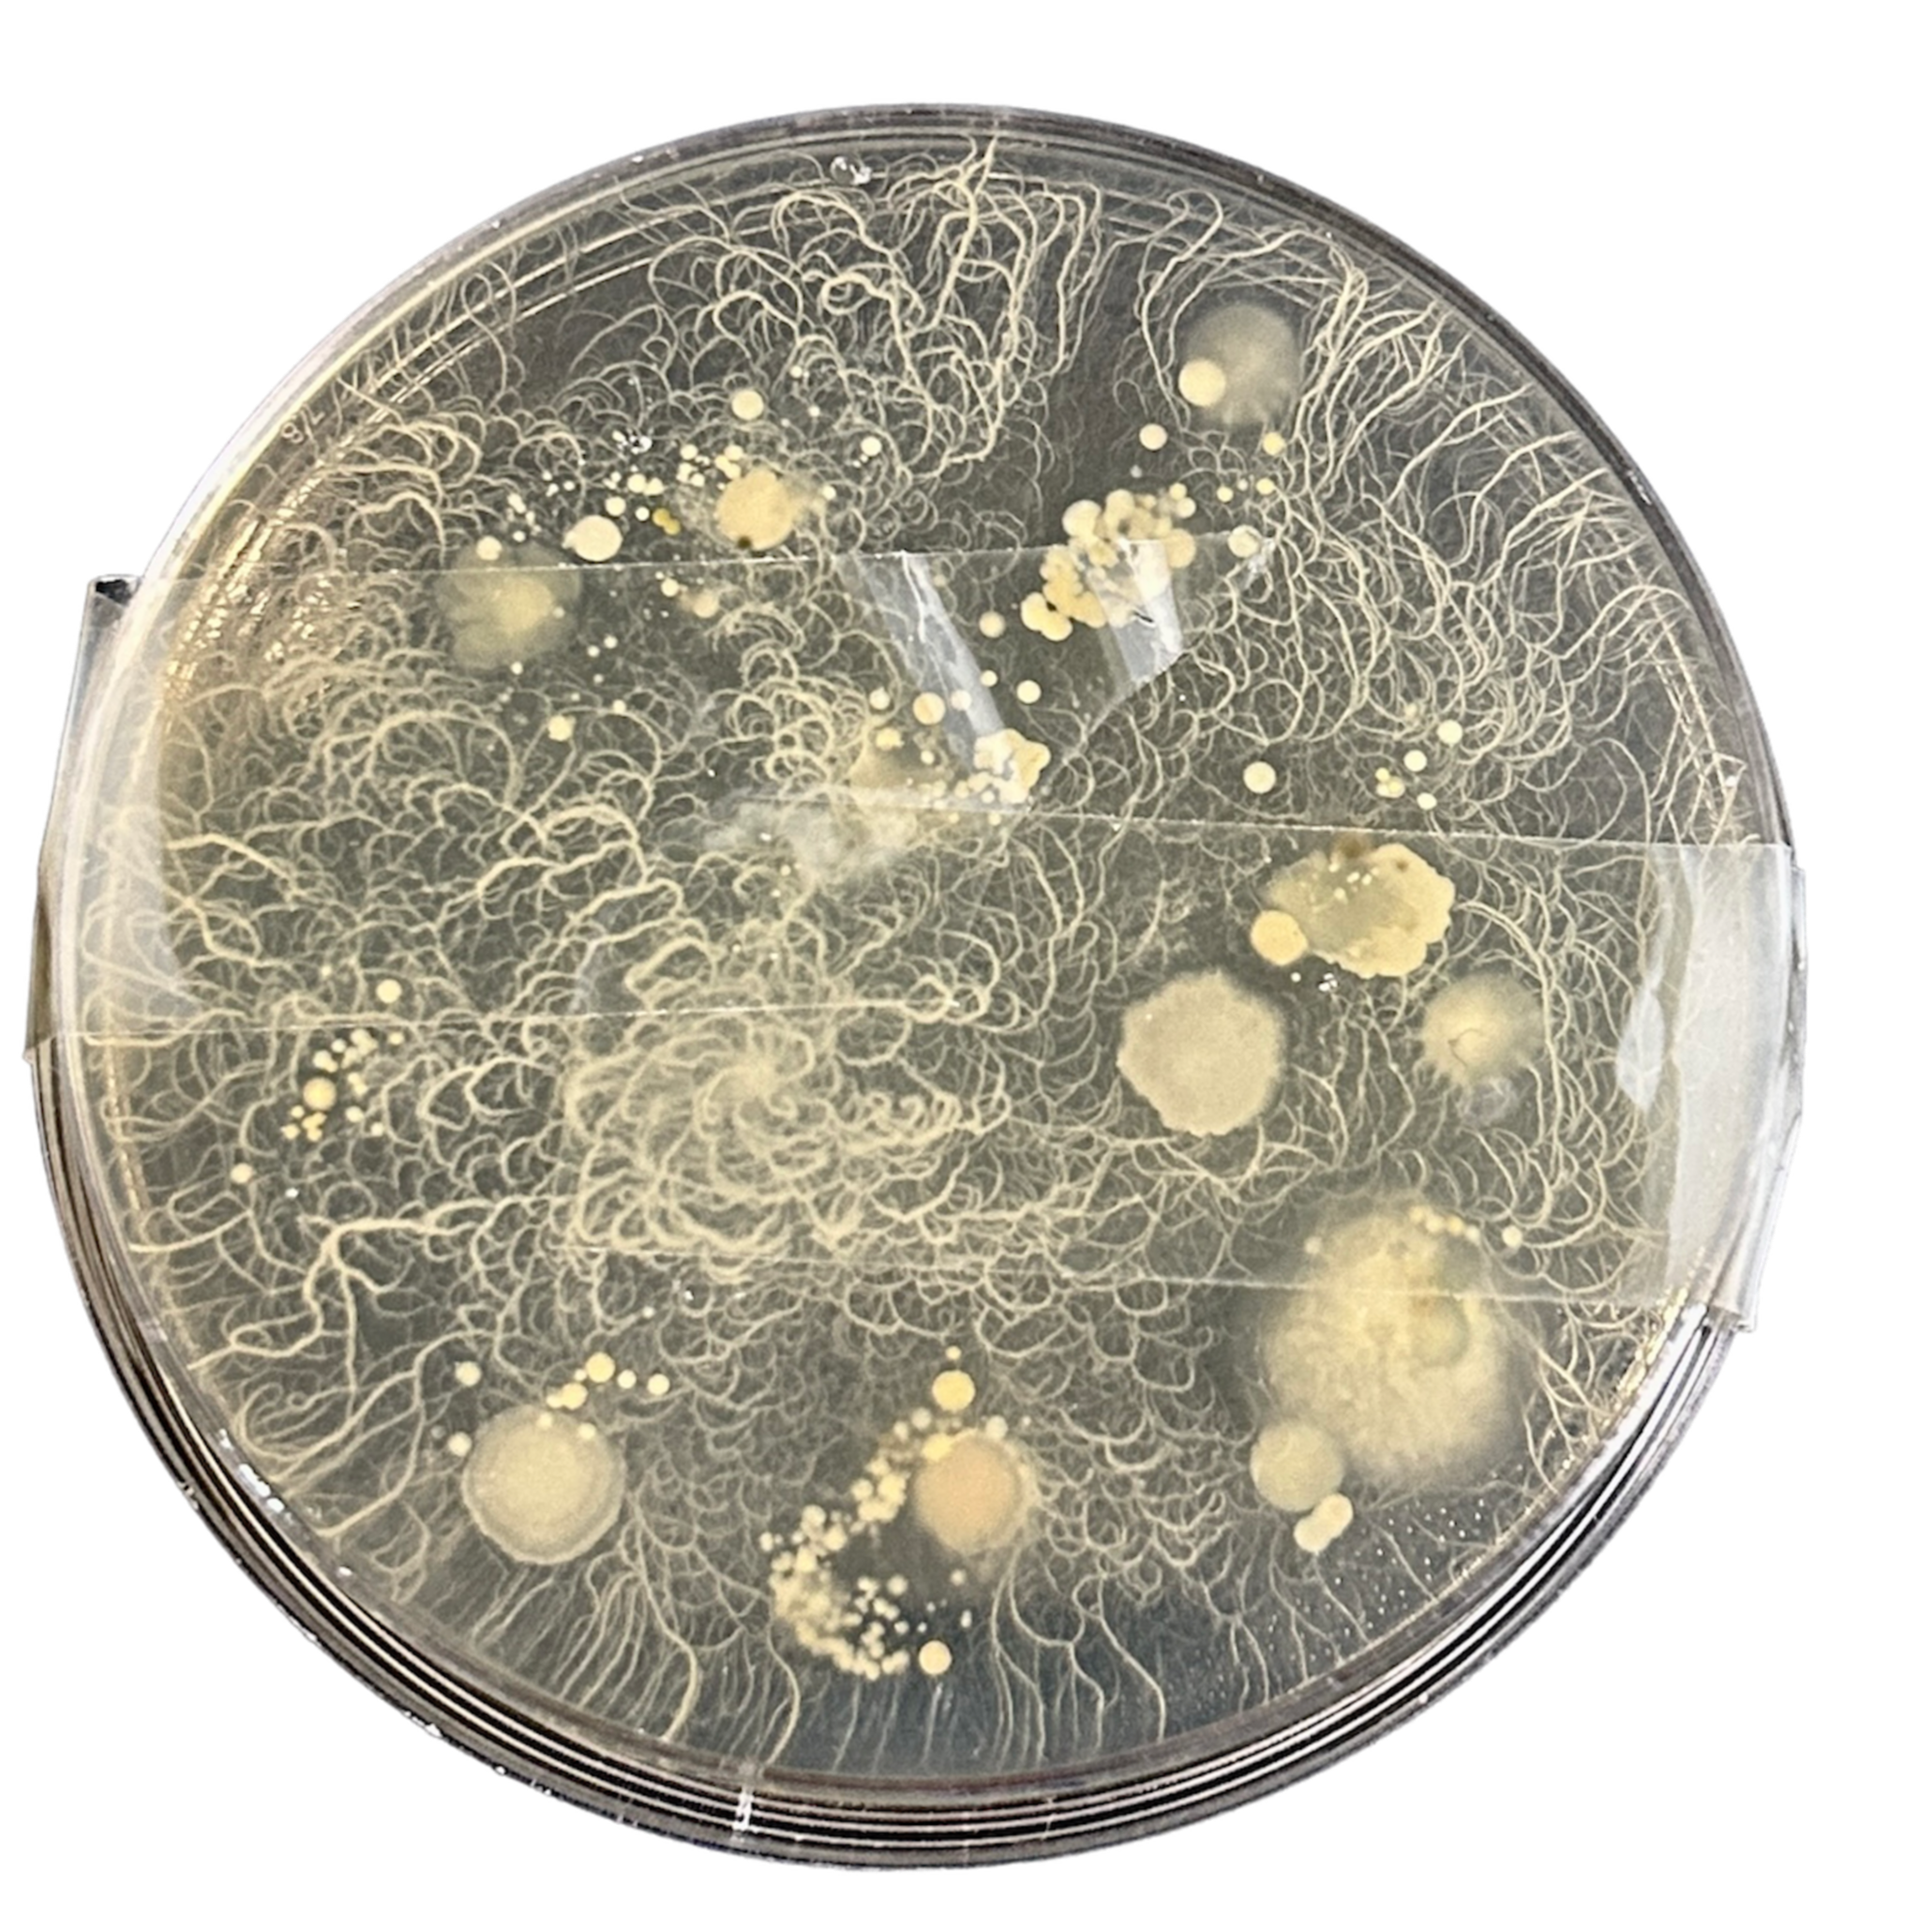
Finger Prints

Artist Research
Susannah King
Susannah King is 4th generation goldsmith who creates one-of-a-kind pieces adorned with gemstones. After working internationally, and being recognised by names such as Paul Smith and Farfetch, Susannah chose to create unique pieces and bespoke items to encourage a ‘sense of individuality’ within the jewellery industry.
Her studies in jewellery started at the British Academy of Jewellery in London and then completed a formal apprenticeship with her father. From here she has exhibited her creations at London Fashion Week and Jewellery Cut Live.

£1,650

£850

£2,600
I first became aware of Susannah's work through social media and her viral videos about wax carving. She regularly releases new collections, with one of her most recent collections 'Voyager' being inspired by space, planets and moons in our solar system. Her videos on social media have been one of the primary ways she markets her work, consequently hitting a younger demographic who often enjoy her bold use of colour and statement pieces.
£7,800
'This ring is inspired by our home planet. The aquamarine centre stone reminds me of the beautiful blue skies with gorgeous fluffy clouds. It’s a celebration of the sunrise in the morning. A fresh new day, like a bright awakening of the refreshed self. I wanted to create a party-style, bouquet for the hand that transmits this idea of newness and revitalisation'

£2,150


Since Susannah's mother was a gemologist, her work is focused heavily on using an array of stones, both natural and lab-grown. She is not afraid to experiment with a range of different coloured stones, creating pieces that can have rainbow-coloured pallets and uses stones with completely different properties and cuts. Her creative stone settings and wax carvings are what have inspired my practice, still incorporating classic designs but with a twist, such as Toi et Moi rings. She is also passionate about the ethical side of her brand, with website profits going towards sustainability charities. She reuses old stones and gold rather than sourcing new, and has created a 100% vegan brand. This means no animal products, such as pumice, are used throughout her making process.
The reason I have chosen to research Susannah King is not only her creative use of wax carving and stone setting but also her relationship with her work and her business. She creates the work she wants drawing inspiration from her personal life as well as the world around her. Her use of both natural and lab-grown stones is also inspiring as many jewellers choose one or the other. However, she caters to both, offering pieces in different price ranges. The use of social media and her marketing is similar to the way I hope to promote my pieces in the future. I admire her use of colour within her practice and the way she does not limit herself to one particular style or product. She has created rings, necklaces and earrings all drawing from different inspirations and influences, for example, art deco and maximalism.
Sources:
- https://www.susannahkinglondon.com/about-1
- https://jewellerycut.com/the-next-generation-goldsmith/
- https://www.talentedladiesclub.com/articles/interview-with-susannah-king-founder-of-susannah-king-london/
Gill Mallet



Gill Mallet is a Bristol-based jeweller with over 40 years of experience in jewellery design and making. She specialises in designing contemporary and unique jewellery in various materials, including silver, palladium and platinum, as well as 9ct and 18ct gold. These solid pieces are then often embellished with an array of high-quality stones.
Mallet's designs are often inspired by the unexpected results of materials and techniques, testing and pushing the limits of the materials she uses. She says "Surprise outcomes allow me to look at my creations from a different perspective and can lead to new and interesting contrasts, textures and juxtapositions". This was shown in her collection 'Fire and Ice' where she dropped molten metal onto ice and used stone-setting to create dynamic and fascinating results.



Mallet's designs and technical perfection drew me to her work, as well as her creative use of stone-setting. Her use of unexpected materials is also rather fascinating, as these often result in one-of-a-kind pieces, as well as embracing the unexpected. As my work is gravitating towards trying to be as technically accurate as possible, the idea of embracing the unexpected is something I would like to explore more. A considerable number of these pieces also remind me of cells and cell structure. I'm often inspired by biology and the idea of bio-jewellery, so this is also something to explore in depth throughout this project, potentially working with unpredictable substances, like growing bacteria.




Sources:
- La Rochefoucauld, J. W. (2014) 21st-Century Jewellery Designers : an Inspired Style. Woodbridge: Antique Collectors’ Club.
- http://www.gillery.co.uk/shop/?p=2&typ_id=2
Collaborative Research Assignment
Sketchbook - Initial Ideas






Here are some of my initial design ideas. I have tried to keep them very loose and experiment with different materials and techniques. I have used a combination of pen, watercolour and oil pastels to create these designs.
Exploring Bacteria as a Material


Above is a step-by-step guide on how to grow bacteria. I want to experiment with this and use the bacteria to make some 'stones', which I will later use with stone setting techniques. I have thought about how to do this and while classic resin would most likely be the most effective way to do so, I want to try and avoid this due to ethical and environmental considerations. I plan to experiment with alternatives like bio-resin, a 100% biodegradable material. However, I would need to take into account the feasibility of encasing cultivated bacteria in a biodegradable product.
Sources:
- https://www.astrazeneca.com/content/dam/az/media-centre-docs/article_files/articles-2020/11229%20-%20AZ-USASEF-Agar-Experiment-v7-STEM-Day-Version-GY-FH.pdf
Biojewellery
"By talking about science breakthroughs as designers, we can make objects and engage the public, their imagination and their desires and so on,"
In 2006, a group of artists from the Royal College of Art collaborated with bioengineers from Kings College London to create a series of rings for three couples, made from their significant others' bone tissue. The project was aimed to ignite public debate about bioengineering, and its other uses.
The rings were made from a bioglass material, which is porous, and mimics the structure of the bone. Bone cells, called osteoblasts, were taken from the couples' jawbones after a wisdom tooth extraction. This caused many ethical debates about the procedures and involved a lot of persuading the surgeons. After 'seeding' the bioglass with the osteoblasts, the bone cells grow into the bioglass structure, replacing it with bone material. These final bone tissue structures were then turned into rings by jewellers.
The images below show the work created by the team. This shows how this can be an innovation on both the scientific side (stem cell usage was a relatively new procedure at the time) in addition to the symbolic reasons for wearing a ring.








Sources:
- Thompson, I. and Stott, N. and Tobie Kerridge (2006) Biojewellery. London: Oral and Maxillofacial Surgery.
Available at: https://research.gold.ac.uk/id/eprint/2317/2/biojewellery-booklet.pdf
Market Research
As I have chosen 'Collect' as my submission, I was tasked to look at the market and demographic that Collect has, as well as craft as a whole.
I started by looking at the Craft Council Dashboard, the organisation that runs Collect, and I found various collections of data, released in May 2020. This included an interactive data tool by which you could filter and see separate pieces of data taken from Collect. This survey had a sample size of 5,392.
Purchasing Handmade Crafts
This chart shows the percentage of people who had bought handmade crafts over the past two years. Within the sample, there was no one who hadn't bought any handmade crafts.
Types of Craft
This graph shows the types of craft people would consider buying in the future. It is reassuring to see that jewellery is fourth on the list as I imagine my practice is going to be heavily jewellery-focused in the future. It is encouraging to see that jewellery came higher than ceramics within the potential buyers' market, showing that while ceramics was the most popular type of craft bought, jewellery is becoming increasingly popular and more buyers are potentially branching out into different mediums.
It is also interesting that 56% of buyers have purchased work made with other mediums, for example, resin. As I hope to use resin in this project, this is encouraging to see this as I know there are some ethical concerns surrounding its usage. As a result, I will be taking ethical considerations into account and testing alternative mediums, for example, biodegradable resin.
Crafts Activities in Spare Time
From the survey, only 11% of people had participated in jewellery, metalwork, pottery, mosaics and/or calligraphy in the last 12 months. This makes me think that since jewellery-making can be time-consuming, potentially more people would be willing to purchase the handmade craft, rather than making it themselves.
Risks When Buying
From this graph, you can see that people are willing to take a risk when buying crafts from a lesser-known maker, and only 17% of people said that they would avoid buying handmade crafts if they didn't know the names of the artists. This is interesting to me as I thought that more people would be hesitant when purchasing handmade crafts from unknown artists. However, this may vary depending on how high the price is. Within Collect, the prices of pieces can vary between £200 and £50,000 and people may want to know more about the artist before committing to higher price points.
Age
This graph shows that the age range for both buyers and potential buyers is 16-34. I believe that my work targets this market so I don't feel I have to change my style to potentially fit this particular demographic. However, I would like to include different styles of work so that every age range could enjoy it.
Marketing
This graph shows the types of social media people have used in the past month (from 2020). I would use this to look at different ways to market my work. For example, I would use Facebook more than I originally thought as 71% of people had used it in the past month. However, I do think this may be slightly outdated as only 4% of people had used TikTok. TikTok gained popularity during lockdown and has kept growing ever since, while I understand the target demographic for the social media app is 14-22 year-olds, I do believe more people aged over 22 are using it today, over 3 years later. I hope to increase my online presence and be confident about using social media to market my work, much as Susannah King does.
Market For Craft - Full Report (2020)


These graphs are taken from the 'Market For Craft' report from 2020, released by the Craft Council. I have picked out these two tables that identify the different subgroup personae and the different crafts they invest in. Jewellery was in the top three disciplines for each category, with some of the top routes for purchasing being craft fairs and design shops. This has shown me the importance of being proactive when showcasing my work, identifying that I will need to apply to fairs and shop spaces to make myself known.
In addition, the next table shows the top three routes for online purchasing of crafts, with Etsy and the maker's website being the most popular platforms. I enjoy making websites and feel confident in making a website shop when the time comes. Some of the top motivations for buying these crafts are that they are 'unique gifts' and for the admiration of human skill. These are both elements I want to explore and challenge in my practice. I enjoy having a connection in my work between the wearer and the object and so I feel as if I can develop this more in my practice to appeal more widely to buyers.
One way I hope to do this is by growing bacteria and making 'stones' from it. Some potential ideas I have had for this bacteria would be either from the wearer themself or a specific location, perhaps somewhere significant to them.
Sources:
- https://application.marketsight.com/app/ItemView.aspx?ID=e3a4df37-0af8-4045-8158-acc400f868c7
- https://www.craftscouncil.org.uk/documents/880/Market_for_craft_full_report_2020.pdf (Page 62-63)
Collect 2023
‘Collect is the leading international art fair for contemporary craft and design, representing the pinnacle of artistry and creativity.’
Every year the Crafts Council showcase artworks made in the past five years by living designers at Somerset House, London. These artworks are carefully selected by an ‘expert advisory panel’ (Crafts Council 2023), with 400 artists being represented, from 40 galleries from across the world, including Asia and Europe.
In 2023 the Crafts Council released figures from their art fair earlier in the year.
Over 12,600 visitors to Somerset House to witness the collection in person, with another 6,730 experiencing the fair online, held via Arsty.net. This meant the overall audience of the collection was 19,330, the most successful year so far.
Approximately 500 of these guests are private tour participants affiliated with esteemed VIP partners such as V&A Museum, Bonhams, Calico Club, and Cromwell Place – all of which are influential figures in the craft market. The opportunity for artists to showcase their work to these agencies, museums, art advisory groups etc, opens the possibility of securing investments into their practice, this could be through galleries or even programmes, like Collect Open.
2000 Private Viewing invitations are distributed to corporates, for example, HSBC, Barclays Wealth and, Rolls Royce Clients. This gives them ‘exclusive insight into contemporary art’, as well as an insight into the craft market, and buying trends' (Crafts Council 2023)
Many interior design and architectural agencies are invited to collect, including Calico Club and The British Institute of Interior Design. This has often led to pieces being sold for high-end clientele, as well as a number of commissioned pieces.
In addition, many museums and galleries visit Collect. 'Collect is the favourite hunting ground for passionate museum curators and keepers of contemporary craft’, this opens opportunities for designers, as well as exposure to these huge galleries and museums. This includes the likes of the Victoria and Albert Museum and the National Museums of Scotland and Northern Ireland.


Collect also has a large media presence, being partnered with World of Interior Magazine. The magazine has a large social media following, amassing almost 2.9 million followers over their social media accounts, with Facebook having 2 million of those followers. They also have 152,000 readers of the magazine itself (Conde Nest 2023). As for the rest of the media campaign, a huge PR campaign was undertaken. This included 140 pieces of media coverage (print, online and social), 46 articles in ‘top-tier’ media, and 13 1:1 interviews. They targeted ‘luxury, high-end titles to attract the best journalists from the leading publications all over the world’. Through the media, Collect reached 709M people reading from The Guardian, The Times, ELLE, and many more outlets.


The Crafts Council promote their marketing campaign both online and in print. They achieve this through social media, websites and the Arsty.net online fair, as well as Crafts Magazine and World of Interiors. Of the 6.7K viewers on Arsty.net, 62% were from the USA, 26% from the UK and 12% from the rest of the world. This shows the demand for craft and Collect is not only in the UK, but is also reaching the US and the rest of the world. Collect has had an increase in its following on Instagram in the past year, with an additional 22.6K followers, showing a rise of 50% from 2022. It has also had 90.1K unique visits to the Collect webpages across the campaign.
Collect is a highly successful craft fair for both the practitioners it represents and the public who visit. 85% of visitors this year said that they would return the following year, and 96% said that the quality of the work shown was ‘very good’ or ‘good’. 96% of the exhibitors shown said Collect expanded their existing buying audience, and 87% of exhibitors said Collect increased their exposure to museum professionals (Craft Council 2023). Both of these figures highlight the success of exhibiting at Collect, and what it does for the craft industry.
Pricing of Collect
The pricing of Collect varies vastly, with pieces going from anywhere between £200 and £50,000. Jewellery pieces tend to be in the £1,000 - £10,000 range, with the highly embellished pieces being towards the higher end. In the pricing lecture, we were shown how many artists price their work and in the case of jewellery, materials had one of the biggest impacts. After this session, I decided to look at the pricing of a piece from Collect a few years ago and attempt to break down the price of the stones used in the ring. This was a rough estimate since gemstone dealers have very different prices. I used prices from one of the most popular dealers in the UK and I decided to focus on the stones. I was not able to estimate how much gold was used, or the labour time involved in making the ring.
As I said before, this was a very rough estimate, however, has given me practice for when it comes to pricing my own work.
The artist, Lisa Rothwell-Young had shown this bespoke ring at Collect a few years ago, her practice only uses fairtrade and ethical stones, hence why the price of stones is higher than what you might expect.
Collect 2023 Examples
As I have never been to Collect, I decided to look at their online collection from 2023 to identify the different types of jewellery and artists they showcase. This has made me think about my material selection for my final piece, including the metals and the stones involved.
*Many of the jewellery pieces exhibited did not have a price available
Finding Opportunities
Exhibition


“Rising Stars is a curated, national platform to foster and champion new talent, early career makers, including students and graduates from BA and MA crafts, design, and applied arts programmes across the UK.”
Rising Stars provides new makers with an initial entry point into the market by featuring their work in a carefully curated selling exhibition.
The programme consists of an exhibition at New Ashgate Gallery in Farnham, enabling new makers to connect with collectors and other marketplaces. This professional development would enhance knowledge transfer on popular topics like marketing and pricing. As well as this, the programme helps makers understand how to gain new connections and manage them.
Every year, 20-25 makers are chosen for the exhibition, and one maker is selected by the panel for a £1000 professional development bursary.
Further opportunities are also available, for example, a showcase at Handmade festivals.
I believe participating in this exhibition would be beneficial for me, especially since I lack experience in pricing and marketing. These are both fundamental foundations when having a business and would support me with a client base. As there has been a significant increase in the price of materials over the past few years, the £1000 bursary would help enable me to extend my practice. This would offer experience with new materials and help me build a professional portfolio, that would show I am capable with such materials. For me, this would include the use of different metals, for instance, gold and platinum, as well as the use of precious stones. This would also help with the cost of materials like files, wax and potentially bigger appliances, like an enamelling furnace.
Source: https://www.newashgate.org.uk/information-for-artists/rising-stars-2024
Residency


A map showing the distance between the residency and where I have stayed
"Stop the information overflow, go offline and get back to focus in a supportive, natural environment in the middle of the Northern summer."
The Back to Basics residency program provides artists with the chance to step away from everyday distractions, like technology, and ‘rediscover the basis of their being’. The emphasis of the residency is reconnecting with your creative practice and going back to the basics of making, and why you made. No project plan is required so you are free to make whatever you want without having to stick to any sort of plan, allowing the creative flow to take its path. There is an emphasis on connecting with other artists on the residency as well as reflecting on your practice and letting yourself be inspired by the surroundings.
I feel as if going back to basics with my making would be beneficial to me. Throughout A-Levels, my foundation, and this degree I have tried many techniques and materials, which I am glad about. However, sometimes I feel as if I’m constantly searching for what my practice will look like. While I feel satisfied with how my practice is starting to take shape, I want to go back and question why I make. What has drawn me to stone-setting and wearables? And what am I inspired by? One thing I know for sure is that I am inspired by Scandinavian design and Finland itself. Having Finnish heritage has meant that I have spent summers on a Finnish lake, and after returning I always feel a sense of rejuvenation and readiness to create. Having the opportunity to create while in a similar setting seems like the obvious place to do a residency and could potentially be what takes my practice to a further level.
Source: https://www.arteles.org/back_to_basics_residency.html
Competition
The British Craft Directory was created to support the community of British artists who are trying to fight their way through the corporate advertising and mass-produced products that are out there and to shine a light on the handicrafts that they are making. This serves as a platform for self-made designers to present their creations in the best way possible, catering to potential retail customers.
This competition would be valuable to my practice as it would help me connect with new makers, and get my name out there. I’m constantly being inspired by other artists and the opportunity to show my work with others would be a valuable experience. The collaboration between artists is welcomed, as well as having open and honest conversations about each other's businesses. I feel as if this would help my practice from a professional standpoint, gaining advice and experience from real-world situations.
Artists who show their work at BCD are then in for the opportunity to be chosen for various cash prizes, something that would help with materials costs for my growing practice.
Source: https://britishcraftdirectory.co.uk
Funding
"This is our fund open to independent creative and cultural practitioners. It supports you to take time to focus on your creative or cultural development and take you to the next stage of your practice."
Developing Your Creative Practice is a funding opportunity created by Arts Council England, with funds provided by National Lottery players. You can apply for up to £12,000 to help develop your practice and need to have a clear plan of how to do so. Developing Your Creative Practice is an extremely competitive funding opportunity, and so having a clear plan for the funding is incredibly important.
While my practice hasn't reached a point for me to realistically apply for this funding, it is most certainly one to keep in mind. One of the huge benefits of applying is that while you may not receive funding, you get feedback as to why this is. I feel as if this makes this funding opportunity a no-brainer, gaining feedback if I get the grant or not. As well, if you don't receive funding, you can apply again next year, after taking on the feedback they have given you.
Source: https://www.artscouncil.org.uk/dycp
Growing Bacteria
From my previous project, I have become very interested in using 'alternative' stones. In my last project, these were basse-taille pieces of silver, and for this project, I want to use bacteria. This was from being inspired by Gill Mallet's work as it reminded me of bacteria. I'm also interested in exploring the wearers' relationship with the jewellery they wear. I plan to create stones made from bacteria that is close to the wearer.
For these examples, I have grown bacteria from myself, close friends, my dogs and around my house.


To grow the bacteria, I needed to start with agar plates, so the bacteria had the optimal conditions to grow. From research, I found that using nutrient agar plates had the highest success rate when cultivating common bacteria.
I used sterile swabs and sampled six different areas to grow, then labelled each plate so I could track how each sample grew. I also tried to use the correct methods when transferring the bacteria to the agar plates, this meant swabbing in different directions to completely cover the plate, while only overlapping small areas. This is meant to provide a higher concentration of bacteria in the first segment, and slightly decrease as you go around the plate so you can see a difference in the levels of bacteria needed for growing. If I was doing this in a lab, I would have used metal swabs and used a Bunsen burner to remove a small amount of bacteria after each swab. However as I just wanted to focus more on the patterns and growth of the bacteria, I decided not to do this.
After 7 days in a dark, dry, and warm environment, these were my results.
Bedroom Carpet

Dogs
Keyboard

Cheek

Friends Finger Prints
Finger Prints
From using the scientific method to apply the bacteria to the plate, I feel as if you can see some bacteria grow in that direction. This example contained more of a fibrous bacteria which produced some strong, straight lines where I had swabbed, and even had a part with a higher concentration of bacteria growth where I had overlapped my swabs.
Identifying Bacteria
After growing the bacteria, I decided that I wanted to try and identify what I had grown. I felt as if this was important to know what I had grown, and if these were common cultures and why had they grown in the way they had. I found this quite difficult, however, it has given me more insight into the bacteria, as well as giving me some ideas for development.
Sources:
Bacteria Jewellery
While growing the bacteria I have thought about what narrative I want for this project, and how my pieces would fit within Collect's market. Bacteria are often seen as 'gross' or 'unhygienic'. However, throughout this project, I have seen it more as a sense of personal connection and a reminder of someone or something, hence using my dogs and a friend as examples. Everyone has very different bacteria on their body and is individual to that person, much like hair, which was used in Victorian hair lockets. My plan for this project is to defy the stigma against bacteria and show it in a new light. I want to create modern jewellery that has a personal connection to each wearer, similar to the bone marrow rings, and highlight that bacteria can become something more than common misconceptions and being 'gross'. Looking at the works shown at Collect, it is clear that I want to use stone-setting techniques in my work as well. This is something I want to practice and explore how the use of stone-setting can inform and communicate ideas. I also want to use high-quality materials, which are often shown at Collect.






